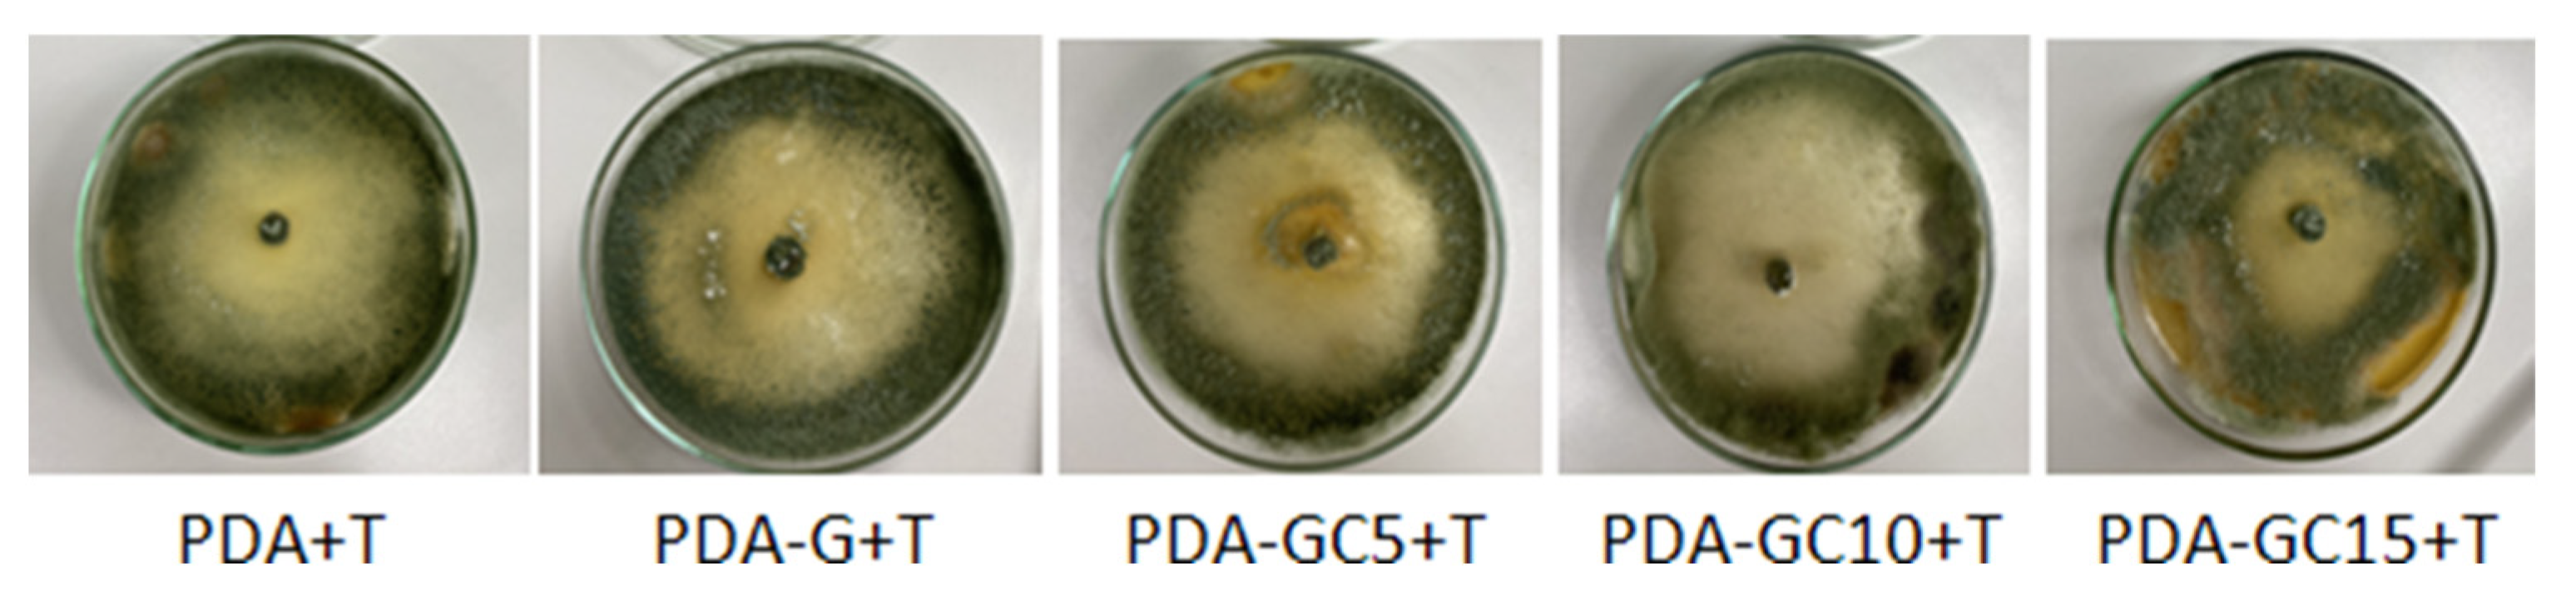
Molecules 26 05755 g011

Gelatin Reinforced with CNCs as Nanocomposite Matrix for Trichoderma harzianum KUEN 1585 Spores in Seed Coatings
Abstract
:1. Introduction
2. Results and Discussions
2.1. Film Characterization
2.1.1. Fourier Transform Infrared Spectroscopy
2.1.2. X-ray Diffraction (XRD)
2.1.3. Scanning Electron Microscopy (SEM)
2.1.4. Water Vapor Sorption Measurements
2.1.5. Moisture Adsorption Test
2.1.6. Determination of Swelling Degree
2.1.7. Water Contact Angle Measurements
2.1.8. Dry-In Time of Water Droplets on the Surfaces and Absorption
2.2. Evaluation of Seed Coating Influence on Seed Germination
2.2.1. Compatibility Test
2.2.2. Viability of T. harzianum KUEN 1585 on Corn Seeds Test
2.2.3. Germination Test
3. Materials and Methods
3.1. Materials
3.2. Film Preparation
3.3. Film Characterization
3.3.1. Fourier Transform Infrared Spectroscopy
3.3.2. X-ray Diffraction
3.3.3. Scanning Electron Microscope
3.3.4. Water Vapor Sorption Measurements
3.3.5. Moisture Adsorption Test
3.3.6. Determination of Swelling Degree
3.3.7. Contact Angle Measurements
3.3.8. Dry-In Time of Water Droplets on the Surfaces and Absorption
3.4. Seed Coating
3.4.1. Compatibility Test
3.4.2. Viability Test
3.4.3. Germination Test
3.4.4. Statistical Analysis
4. Conclusions
Author Contributions
Funding
Institutional Review Board Statement
Informed Consent Statement
Conflicts of Interest
Sample Availability
References
- Li, X.; Liu, A.; Ye, R.; Wang, Y.; Wang, W. Fabrication of gelatin–laponite composite films: Effect of the concentration of laponite on physical properties and the freshness of meat during storage. Food Hydrocoll. 2015, 44, 390–398. [Google Scholar] [CrossRef]
- Feng, T.; Su, Q.; Zhuang, H.; Ye, R.; Gu, Z.; Jin, Z. Ghost structures, pasting, rheological and textural properties between Mesona blumes gum and various starches. J. Food Qual. 2014, 37, 73–82. [Google Scholar] [CrossRef]
- Chen, Y.; Ye, R.; Li, X.; Wang, J. Preparation and characterization of extruded thermoplastic zein–poly (propylene carbonate) film. Ind. Crop. Prod. 2013, 49, 81–87. [Google Scholar] [CrossRef]
- Pereda, M.; Ponce, A.G.; Marcovich, N.E.; Ruseckaite, R.A.; Martucci, J.F. Chitosan–gelatin composites and bi-layer films with potential antimicrobial activity. Food Hydrocoll. 2011, 25, 1372–1381. [Google Scholar] [CrossRef]
- Monteiro, M.K.S.; dos Santos, F.K.G.; Leite, R.H.D.L.; Aroucha, E.; Vitoriano, J.O.; Oliveira, V.R.L. Hydrophilicity, solubility and optical properties in composite films of gelatin and bentonite clay in its natural form or modified. Mater. Sci. Forum 2018, 912, 136–140. [Google Scholar] [CrossRef]
- Wang, Y.; Liu, A.; Ye, R.; Wang, W.; Li, X. Transglutaminase-induced crosslinking of gelatin–calcium carbonate composite films. Food Chem. 2015, 166, 414–422. [Google Scholar] [CrossRef] [PubMed]
- Gómez-Guillén, M.C.; Perez-Mateos, M.; Gómez-Estaca, J.; López-Caballero, E.; Giménez, B.; Montero, P. Fish gelatin: A renewable material for developing active biodegradable films. Trends Food Sci. Technol. 2009, 20, 3–16. [Google Scholar] [CrossRef] [Green Version]
- Suderman, N.; Isa, M.I.N.; Sarbon, N.M. The effect of plasticizers on the functional properties of biodegradable gelatin-based film: A review. Food Biosci. 2018, 24, 111–119. [Google Scholar] [CrossRef]
- Yadav, M.; Chiu, F.-C. Cellulose nanocrystals reinforced κ-carrageenan based UV resistant transparent bionanocomposite films for sustainable packaging applications. Carbohydr. Polym. 2019, 211, 181–194. [Google Scholar] [CrossRef]
- Gicquel, E.; Martin, C.; Yanez, J.G.; Bras, J. Cellulose nanocrystals as new bio-based coating layer for improving fiber-based mechanical and barrier properties. J. Mater. Sci. 2017, 52, 3048–3061. [Google Scholar] [CrossRef]
- Cacciotti, I.; Fortunati, E.; Puglia, D.; Kenny, J.M.; Nanni, F. Effect of silver nanoparticles and cellulose nanocrystals on electrospun poly (lactic) acid mats: Morphology, thermal properties and mechanical behavior. Carbohydr. Polym. 2014, 103, 22–31. [Google Scholar] [CrossRef] [Green Version]
- Leite, L.S.; Ferreira, C.M.; Corrêa, A.C.; Moreira, F.K.; Mattoso, L.H. Scaled-up production of gelatin-cellulose nanocrystal bionanocomposite films by continuous casting. Carbohydr. Polym. 2020, 238, 116198. [Google Scholar] [CrossRef] [PubMed]
- Accinelli, C.; Abbas, H.K.; Shier, W.T. A bioplastic-based seed coating improves seedling growth and reduces production of coated seed dust. J. Crop. Improv. 2018, 32, 1–13. [Google Scholar] [CrossRef]
- Tekrony, D.M. Seeds: The delivery system for crop science. Crop. Sci. 2006, 46, 2263–2269. [Google Scholar] [CrossRef]
- Kipngeno, P.; Losenge, T.; Maina, N.; Kahangi, E.; Juma, P. Efficacy of Bacillus subtilis and Trichoderma asperellum against Pythium aphanidermatum in tomatoes. Biol. Control 2015, 90, 92–95. [Google Scholar] [CrossRef]
- Locatelli, G.O.; dos Santos, G.F.; Botelho, P.S.; Finkler, C.L.L.; Bueno, L.A. Development of Trichoderma sp. formulations in encapsulated granules (CG) and evaluation of conidia shelf-life. Biol. Control 2018, 117, 21–29. [Google Scholar] [CrossRef]
- Nicolopoulou-Stamati, P.; Maipas, S.; Kotampasi, C.; Stamatis, P.; Hens, L. Chemical pesticides and human health: The urgent need for a new concept in agriculture. Front. Public Health 2016, 4, 148. [Google Scholar] [CrossRef] [Green Version]
- Cacciotti, I.; Pallotto, F.; Scognamiglio, V.; Moscone, D.; Arduini, F. Reusable optical multi-plate sensing system for pesticide detection by using electrospun membranes as smart support for acetylcholinesterase immobilisation. Mater. Sci. Eng. C 2020, 111, 110744. [Google Scholar] [CrossRef] [PubMed]
- Pedrini, S.; Merritt, D.; Stevens, J.; Dixon, K. Seed coating: Science or marketing spin? Trends Plant Sci. 2017, 22, 106–116. [Google Scholar] [CrossRef] [PubMed] [Green Version]
- Accinelli, C.; Abbas, H.K.; Little, N.; Kotowicz, J.K.; Mencarelli, M.; Shier, W.T. A liquid bioplastic formulation for film coating of agronomic seeds. Crop. Prot. 2016, 89, 123–128. [Google Scholar] [CrossRef]
- Bettiol, W. Biopesticide use and research in Brazil. Outlooks Pest Manag. 2011, 22, 280–283. [Google Scholar] [CrossRef] [Green Version]
- Popescu, M.-C.; Dogaru, B.-I.; Sun, D.; Stoleru, E.; Simionescu, B.C. Structural and sorption properties of bio-nanocomposite films based on κ-carrageenan and cellulose nanocrystals. Int. J. Biol. Macromol. 2019, 135, 462–471. [Google Scholar] [CrossRef] [PubMed]
- Popescu, M.-C.; Vasile, C.; Filip, D.; Macocinschi, D.; Singurel, G. Characterization by Fourier transform infrared spectroscopy of polyethylene adipate/cholesteryl palmitate blends. J. Appl. Polym. Sci. 2004, 94, 1156–1163. [Google Scholar] [CrossRef]
- Popescu, C.-M.; Jones, D.; Schalnat, J.; Segerholm, K.; Henriksson, M.; Westin, M. Structural characterization and mechanical properties of wet-processed fibreboard based on chemo-thermomechanical pulp, furanic resin and cellulose nanocrystals. Int. J. Biol. Macromol. 2020, 145, 586–593. [Google Scholar] [CrossRef] [PubMed]
- Taheri, P.; Jahanmardi, R.; Koosha, M.; Abdi, S. Physical, mechanical and wound healing properties of chitosan/gelatin blend films containing tannic acid and/or bacterial nanocellulose. Int. J. Biol. Macromol. 2020, 154, 421–432. [Google Scholar] [CrossRef]
- Kong, J.; Yu, S. Fourier transform infrared spectroscopic analysis of protein secondary structures. Acta Biochim. Biophys. Sin. 2007, 39, 549–559. [Google Scholar] [CrossRef] [Green Version]
- Li, K.; Jin, S.; Chen, H.; Li, J. Bioinspired interface engineering of gelatin/cellulose nanofibrils nanocomposites with high mechanical performance and antibacterial properties for active packaging. Compos. Part B Eng. 2019, 171, 222–234. [Google Scholar] [CrossRef]
- Hashim, D.; Man, Y.C.; Norakasha, R.; Shuhaimi, M.; Salmah, Y.; Syahariza, Z. Potential use of Fourier transform infrared spectroscopy for differentiation of bovine and porcine gelatins. Food Chem. 2010, 118, 856–860. [Google Scholar] [CrossRef]
- Popescu, M.-C.; Vasile, C.; Craciunescu, O. Structural analysis of some soluble elastins by means of FT-IR and 2D IR correlation spectroscopy. Biopolymers 2010, 93, 1072–1084. [Google Scholar] [CrossRef]
- Ngarize, S.; Herman, H.; Adams, A.; Howell, N. Comparison of changes in the secondary structure of unheated, heated, and high-pressure-treated β-lactoglobulin and ovalbumin proteins using Fourier transform Raman spectroscopy and self-deconvolution. J. Agric. Food Chem. 2004, 52, 6470–6477. [Google Scholar] [CrossRef]
- Omrani-Fard, H.; Abbaspour-Fard, M.H.; Khojastehpour, M.; Dashti, A. Gelatin/whey protein-potato flour bioplastics: Fabrication and evaluation. J. Polym. Environ. 2020, 28, 2029–2038. [Google Scholar] [CrossRef]
- Ahammed, S.; Liu, F.; Khin, M.N.; Yokoyama, W.H.; Zhong, F. Improvement of the water resistance and ductility of gelatin film by zein. Food Hydrocoll. 2020, 105, 105804. [Google Scholar] [CrossRef]
- Okuyama, K. Revisiting the molecular structure of collagen. Connect. Tissue Res. 2008, 49, 299–310. [Google Scholar] [CrossRef]
- Sun, D.; Onyianta, A.J.; O’Rourke, D.; Perrin, G.; Popescu, C.-M.; Saw, L.H.; Cai, Z.; Dorris, M. A process for deriving high quality cellulose nanofibrils from water hyacinth invasive species. Cellulose 2020, 27, 3727–3740. [Google Scholar] [CrossRef] [Green Version]
- Popescu, M.-C.; Dogaru, B.-I.; Popescu, C.-M. Effect of cellulose nanocrystals nanofiller on the structure and sorption properties of carboxymethyl cellulose–glycerol–cellulose nanocrystals nanocomposite systems. Materials 2020, 13, 2900. [Google Scholar] [CrossRef]
- Kwak, H.W.; Lee, H.; Park, S.; Lee, M.E.; Jin, H.-J. Chemical and physical reinforcement of hydrophilic gelatin film with di-aldehyde nanocellulose. Int. J. Biol. Macromol. 2020, 146, 332–342. [Google Scholar] [CrossRef]
- Pereira, P.F.M.; Picciani, P.H.S.; Calado, V.M.A.; Tonon, R.V. Gelatin-based nanobiocomposite films as sensitive layers for monitoring relative humidity in food packaging. Food Bioprocess Technol. 2020, 13, 1063–1073. [Google Scholar] [CrossRef]
- Li, H.; Shi, H.; He, Y.; Fei, X.; Peng, L. Preparation and characterization of carboxymethyl cellulose-based composite films reinforced by cellulose nanocrystals derived from pea hull waste for food packaging applications. Int. J. Biol. Macromol. 2020, 164, 4104–4112. [Google Scholar] [CrossRef] [PubMed]
- Mondragon, G.; Peña-Rodriguez, C.; González, A.; Eceiza, A.; Arbelaiz, A. Bionanocomposites based on gelatin matrix and nanocellulose. Eur. Polym. J. 2015, 62, 1–9. [Google Scholar] [CrossRef]
- Hanani, Z.N.; Roos, Y.; Kerry, J. Use and application of gelatin as potential biodegradable packaging materials for food products. Int. J. Biol. Macromol. 2014, 71, 94–102. [Google Scholar] [CrossRef] [PubMed]
- Van der Wel, G.; Adan, O. Moisture in organic coatings—A review. Prog. Org. Coat. 1999, 37, 1–14. [Google Scholar] [CrossRef]
- Popescu, M.-C.; Dogaru, B.-I.; Popescu, C.-M. The influence of cellulose nanocrystals content on the water sorption properties of bio-based composite films. Mater. Des. 2017, 132, 170–177. [Google Scholar] [CrossRef]
- Ooi, S.Y.; Ahmad, I.; Amin, M.C.I.M. Cellulose nanocrystals extracted from rice husks as a reinforcing material in gelatin hydrogels for use in controlled drug delivery systems. Ind. Crop. Prod. 2016, 93, 227–234. [Google Scholar] [CrossRef]
- George, J.; Siddaramaiah, J. High performance edible nanocomposite films containing bacterial cellulose nanocrystals. Carbohydr. Polym. 2012, 87, 2031–2037. [Google Scholar] [CrossRef]
- Syahida, S.N.; Ismail-Fitry, M.R.; Ainun, Z.M.A.; Hanani, Z.A.N. Effects of palm wax on the physical, mechanical and water barrier properties of fish gelatin films for food packaging application. Food Packag. Shelf Life 2020, 23, 100437. [Google Scholar] [CrossRef]
- Kavoosi, G.; Rahmatollahi, A.; Dadfar, S.M.M.; Purfard, A.M. Effects of essential oil on the water binding capacity, physico-mechanical properties, antioxidant and antibacterial activity of gelatin films. LWT 2014, 57, 556–561. [Google Scholar] [CrossRef]
- Santos, T.M.; Souza Filho, M.d.S.M.; Cáceres, C.A.; Rosa, M.F.; Morais, J.P.S.; Pinto, A.M.; Azeredo, H.M. Fish gelatin films as affected by cellulose whiskers and sonication. Food Hydrocoll. 2014, 41, 113–118. [Google Scholar] [CrossRef]
- Miao, C.; Hamad, W.Y. In-situ polymerized cellulose nanocrystals (CNC)—Poly (l-lactide) (PLLA) nanomaterials and applications in nanocomposite processing. Carbohydr. Polym. 2016, 153, 549–558. [Google Scholar] [CrossRef] [PubMed]
- Maroufi, L.Y.; Ghorbani, M.; Tabibiazar, M.; Mohammadi, M.; Pezeshki, A. Advanced properties of gelatin film by incorporating modified kappa-carrageenan and zein nanoparticles for active food packaging. Int. J. Biol. Macromol. 2021, 183, 753–759. [Google Scholar] [CrossRef]
- Xiao, Y.; Liu, Y.; Kang, S.; Wang, K.; Xu, H. Development and evaluation of soy protein isolate-based antibacterial nanocomposite films containing cellulose nanocrystals and zinc oxide nanoparticles. Food Hydrocoll. 2020, 106, 105898. [Google Scholar] [CrossRef]
- De Souza Coelho, C.C.; Silva, R.B.S.; Carvalho, C.W.P.; Rossi, A.L.; Teixeira, J.A.; Freitas-Silva, O.; Cabral, L.M.C. Cellulose nanocrystals from grape pomace and their use for the development of starch-based nanocomposite films. Int. J. Biol. Macromol. 2020, 159, 1048–1061. [Google Scholar] [CrossRef]
- Cortés-Rojas, D.; Beltrán-Acosta, C.; Zapata-Narvaez, Y.; Chaparro, M.; Gómez, M.; Cruz-Barrera, M. Seed coating as a delivery system for the endophyte Trichoderma koningiopsis Th003 in rice (Oryza sativa). Appl. Microbiol. Biotechnol. 2021, 105, 1889–1904. [Google Scholar] [CrossRef] [PubMed]
- Swaminathan, J.; van Koten, C.; Henderson, H.; Jackson, T.; Wilson, M. Formulations for delivering Trichoderma atroviridae spores as seed coatings, effects of temperature and relative humidity on storage stability. J. Appl. Microbiol. 2016, 120, 425–431. [Google Scholar] [CrossRef] [PubMed] [Green Version]
- Yonsel, Ş.; Demir, M. Dressing of wheat seeds with the PGP fungus Trichoderma harzianum KUEN 1585. Soil Water J. 2013, 2, 1789–1796. [Google Scholar]
- Mancini, V.; Romanazzi, G. Seed treatments to control seedborne fungal pathogens of vegetable crops. Pest Manag. Sci. 2014, 70, 860–868. [Google Scholar] [CrossRef] [PubMed]
- López-Bucio, J.; Pelagio-Flores, R.; Herrera-Estrella, A. Trichoderma as biostimulant: Exploiting the multilevel properties of a plant beneficial fungus. Sci. Hortic. 2015, 196, 109–123. [Google Scholar] [CrossRef]
- Yonsel, Ş.; Sevim, M. Microbial seed dressing to increase grain yield and quality. In Proceedings of the 15th International Cereal and Bread Congress, Istanbul, Turkey, 17–21 April 2016. [Google Scholar]
- Yonsel, Ş.; Sevim, M. Microbial dressing of sunflower seeds with Trichoderma harzianum KUEN 1585. In Proceedings of the 19th International Sunflower Conference, Edirne, Turkey, 29 May–3 June 2016. [Google Scholar]
- Yonsel, Ş.; Demir, M. Coating of wheat seeds with the PGP fungus Trichoderma harzianum KUEN 1581. New Biotechnol. 2012, 29, S23. [Google Scholar] [CrossRef]
- Kader, M.A. A comparison of seed germination calculation formulae and the associated interpretation of resulting data. J. Proc. R. Soc. N. S. Wales 2005, 138, 65–75. [Google Scholar]
- Supriya, P.; Sridhar, K.; Ganesh, S. Fungal decontamination and enhancement of shelf life of edible split beans of wild legume Canavalia maritima by the electron beam irradiation. Radiat. Phys. Chem. 2014, 96, 5–11. [Google Scholar] [CrossRef]
- Thube, S.H.; Mahapatro, G.K.; Kumar, M.B.A. In vitro evaluation of insecticides, bio-fungicide and bio-fertilizer for strategic and eco-friendly combinatorial seed treatments in chickpea. Proc. Natl. Acad. Sci. India Sect. B Biol. Sci. 2018, 88, 645–654. [Google Scholar] [CrossRef]
- Raju, K.; Radhika, K.; Reddy, K.B.; Naik, V.S. Assessment of the impact of seed treatment and polymer coating on germination and seedling vigour of maize hybrid, DHM 117. Int. J. Chem. Stud. 2019, 7, 373–377. [Google Scholar]

| Code | G, % | CNC, % |
|---|---|---|
| G | 100 | - |
| GC5 | 95 | 5 |
| GC10 | 90 | 10 |
| GC15 | 85 | 15 |
Publisher’s Note: MDPI stays neutral with regard to jurisdictional claims in published maps and institutional affiliations. |
© 2021 by the authors. Licensee MDPI, Basel, Switzerland. This article is an open access article distributed under the terms and conditions of the Creative Commons Attribution (CC BY) license (https://creativecommons.org/licenses/by/4.0/).
Share and Cite
Dogaru, B.-I.; Stoleru, V.; Mihalache, G.; Yonsel, S.; Popescu, M.-C. Gelatin Reinforced with CNCs as Nanocomposite Matrix for Trichoderma harzianum KUEN 1585 Spores in Seed Coatings. Molecules 2021, 26, 5755. https://doi.org/10.3390/molecules26195755
Dogaru B-I, Stoleru V, Mihalache G, Yonsel S, Popescu M-C. Gelatin Reinforced with CNCs as Nanocomposite Matrix for Trichoderma harzianum KUEN 1585 Spores in Seed Coatings. Molecules. 2021; 26(19):5755. https://doi.org/10.3390/molecules26195755
Chicago/Turabian StyleDogaru, Bianca-Ioana, Vasile Stoleru, Gabriela Mihalache, Sems Yonsel, and Maria-Cristina Popescu. 2021. "Gelatin Reinforced with CNCs as Nanocomposite Matrix for Trichoderma harzianum KUEN 1585 Spores in Seed Coatings" Molecules 26, no. 19: 5755. https://doi.org/10.3390/molecules26195755
APA StyleDogaru, B.-I., Stoleru, V., Mihalache, G., Yonsel, S., & Popescu, M.-C. (2021). Gelatin Reinforced with CNCs as Nanocomposite Matrix for Trichoderma harzianum KUEN 1585 Spores in Seed Coatings. Molecules, 26(19), 5755. https://doi.org/10.3390/molecules26195755








